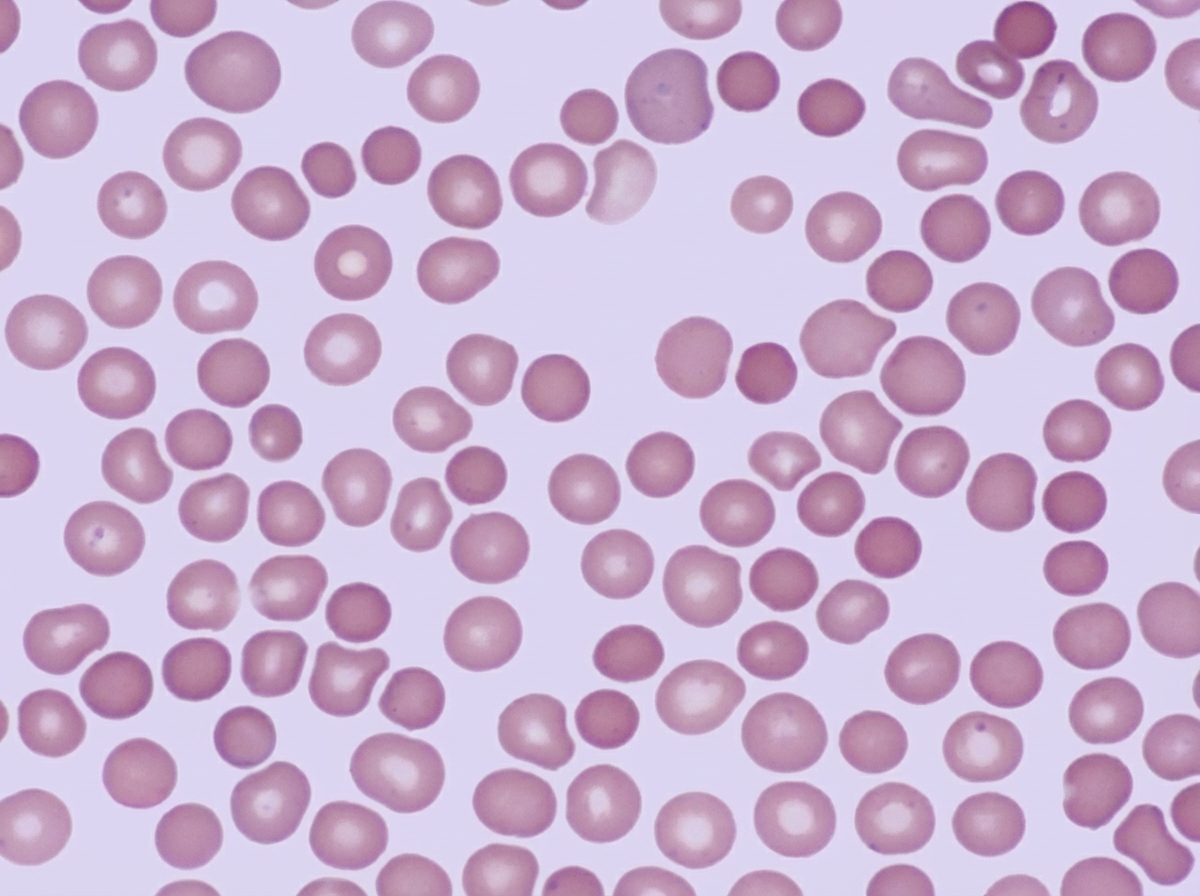
Image for question 94

Enter your email to get your 85% OFF code and unlock the full NEET PG question bank on the app.
What is true about hemochromatosis?
Which of the following is NOT considered a blood component?
What is the most malignant form of Non-Hodgkin Lymphoma (NHL)?
A 23-year-old man of northern European lineage presents with anemia. His father and paternal aunt had a similar illness that was treated successfully by splenectomy. His peripheral blood smear is similar to that shown in the illustration. Which of the following additional abnormalities is expected?
All of the following can cause hemolytic anemia except?
A 56-year-old female presents with headache, dizziness, generalized itching, especially after hot showers, and intense burning in her hands and feet. She reports relief with aspirin. Physical examination reveals splenomegaly and elevated blood pressure. Investigations show HB: 20.1 g/dl, Hematocrit: 60%, WBC: 15800, Platelet count: 500,000/µl, low spO2: 98%, and increased LAP. Which of the following is the most common mutation seen in the condition described?
A decrease in serum iron and a decrease in total iron-binding capacity (TIBC) is seen in which condition?
All of the following are true regarding DVT except?
All except one are unfavourable signs in early Hodgkin's Lymphoma?
A patient presents with a platelet count of 700x10^9/L with abnormalities in size, shape, and granularity of platelets. The WBC count is 12x10^9/L, hemoglobin is 11g/dL, and the Philadelphia chromosome is absent. What is the most likely diagnosis?
Anemia Evaluation and Management
Practice Questions
Hemoglobinopathies
Practice Questions
Thalassemias
Practice Questions
Platelet Disorders
Practice Questions
Coagulation Disorders
Practice Questions
Thrombotic Disorders
Practice Questions
Leukemias
Practice Questions
Lymphomas
Practice Questions
Multiple Myeloma and Plasma Cell Disorders
Practice Questions
Myeloproliferative Neoplasms
Practice Questions
Transfusion Medicine
Practice Questions
Hematopoietic Stem Cell Transplantation
Practice Questions
Get full access to all questions, explanations, and performance tracking.
Scan to download app